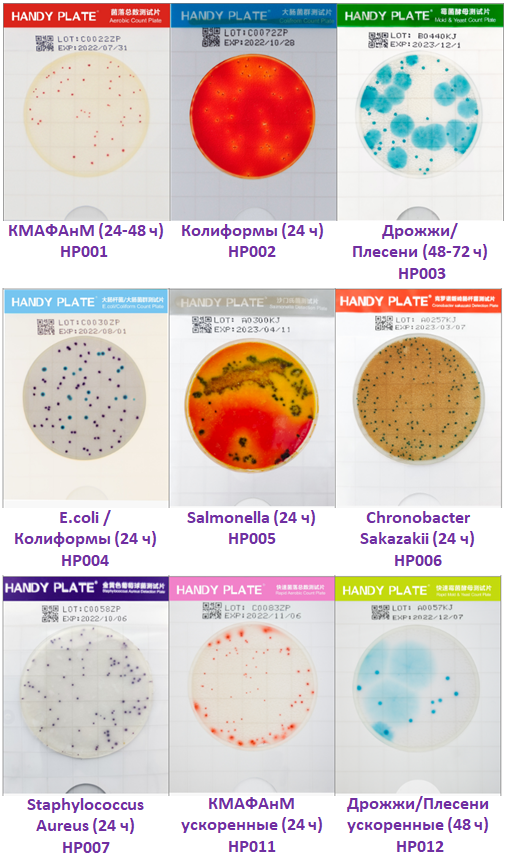
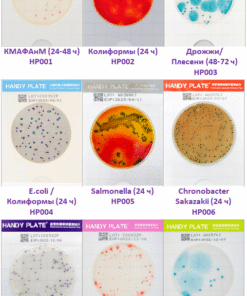

Microbial Test Strips (Handy Plate™). Микробиологические тест-пластины (Handy Plate™)
TOO «Micro Solutions» является официальным дистрибьютором бренда HuanKai — национального высокотехнологичного предприятия, входящего в состав Гуандунского института микробиологии. Основанная в 1993 году, компания HuanKai зарекомендовала себя как надежный производитель высокотехнологичной продукции, соответствующей строгим международным стандартам ISO9001, FDA и GMP
Продукция, которой доверяют лидеры рынка
Ассортимент HuanKai включает более 2000 наименований. Мы гордимся тем, что представляем продукцию, которой доверяют такие мировые лидеры, как PepsiCo, Danone, The Coca-Cola Company, Amway, Bayer AG и многие другие.
Наши решения
Мы предлагаем комплексные решения для лабораторных исследований, охватывающие ключевые направления:
Классическое микробиологическое тестирование: Реагенты и расходные материалы, включая культуральные среды от ведущего бренда HKM.
Экспресс-тесты: Современные решения от бренда BHK (HuanKai Biology) для быстрой идентификации микроорганизмов, производства вакцин и генной инженерии.
Оборудование и расходные материалы: Лабораторные приборы, а также расходники для микробиологических исследований, включая решения для анализа воды и реагенты от бренда CHK.
Моющие и дезинфицирующие средства: Эффективные и экологически безопасные продукты для лабораторий и производственных линий, также разработанные под брендом
Мы гордимся тем, что предоставляем продукцию, которая отвечает самым высоким требованиям качества и надежности.
Тест-пластины Handy Plate™: Простота, точность, надежность
Тест-пластины Handy Plate™ — это современное решение для ускоренного и точного обнаружения и подсчёта санитарно-показательных и патогенных микроорганизмов. Они идеально подходят для анализа продуктов питания, сырья, напитков, воды и других объектов окружающей среды. Являются аналогами известных тест-систем Петрифильм (Petrifilm™)
Handy Plate™ является аналогом известных тест-систем Petrifilm™, но при этом предлагает ряд уникальных преимуществ.
Принцип действия Пластины содержат готовую питательную среду, хромогенные субстраты, индикаторы и селективные добавки, необходимые для выявления целевых микроорганизмов. При посеве образец объёмом 1 мл равномерно распределяется по впитывающей подложке, что делает процедуру быстрой и удобной, не требуя использования распределителя.
Как это работает:
- Внесение образца:Добавьте 1 мл образца в центр пластины.
- Инкубация:Поместите пластину в термостат.
- Подсчёт и интерпретация:Подсчитайте количество колоний. Индикаторные красители окрашивают колонии, облегчая подсчёт и интерпретацию результатов.
Преимущества Handy Plate™:
- Готовы к использованию:Забудьте о приготовлении питательных сред. Handy Plate™ — это готовые тесты, которые помогают избежать ошибок и сэкономить время.
- Высокая эффективность:Сокращают время исследования, обеспечивая при этом надёжный, точный и воспроизводимый результат.
- Простота и удобство:Процедура посева проста и быстра. Пластины не содержат порошка и не требуют использования распределителя.
- Компактность:Пластины занимают значительно меньше места, что облегчает их транспортировку, хранение, инкубацию и утилизацию.
- Длительный срок хранения:Срок годности составляет 18 месяцев, что позволяет хранить их в течение длительного времени без потери качества.
Примеры самых популярных среди клиентов позиций
| Aerobic Count Plate (AC) — Пластина для подсчёта аэробных бактерий (для подсчета КМАФАнМ (ОМЧ)) | HP001 | Пластина для подсчёта общего количества колоний в образцах из пищевых продуктов, напитков и т. д. Индикатор тетразолий способствует образованию красных колоний. Инкубация: 36±1℃, 48h±2h | ![]() |
| Coliform Count Plate (EC) — Пластина для подсчёта колиформ | HP002 | Пластина для подсчёта колиформных бактерий в образцах из пищевых продуктов, напитков и т. д. Индикатор тетразолий способствует образованию красных колоний. Брожение лактозы приводит к образованию кислоты и газа. Инкубация: 36±1℃, 18h-24h
|
![]() |
| Yeast & Mold Count Plate (YM) — Пластина для подсчёта дрожжей и плесневых грибов | HP003 | Пластина для подсчёта дрожжей и плесневых грибов в образцах из пищевых продуктов, напитков и т. д. Индикатор индол способствует образованию сине-зелёных колоний. Инкубация: 28±1℃, 48h-72h | ![]() |
| Staphylococcus Aureus Count Plate (SA) — Пластина для подсчёта колоний золотистого стафилококка | HP007 | Пластина для подсчёта Staphylococcus aureus в образцах из пищевых продуктов, напитков и т. д. Индикатор индол способствует образованию колоний цвета фуксии (пурпурно-красного). | ![]() |
Handy Plate™ — это идеальный выбор для тех, кто ценит надёжность, точность и простоту в работе.
Температура хранения (°C): 2-8 ºC
| Код | Название продукта | Спецификация | Предполагаемое применение |
| HP001 | Тест-пластины для подсчёта аэробных бактерий (для подсчета КМАФАнМ(ОМЧ)) | 20 тестов / упаковка | Подсчёт общего количества колоний |
| HP011 | Тест-пластины для экспресс-подсчёта аэробных бактерий | 20 тестов / упаковка | Экспресс-подсчёт общего количества колоний |
| HP011A | Тест-пластины для экспресс-подсчёта аэробных бактерий (метод мембранной фильтрации) | 20 тестов / упаковка | Экспресс-подсчёт общего количества колоний |
| HP002 | Тест-пластины для подсчёта колиформ | 20 тестов / упаковка | Подсчёт колиформ |
| HP003 | Тест-пластины для подсчёта плесневых грибов и дрожжей | 20 тестов / упаковка | Подсчёт плесневых грибов и дрожжей |
| HP012 | Тест-пластины для экспресс-подсчёта плесневых грибов и дрожжей | 20 тестов / упаковка | Экспресс-подсчёт плесневых грибов и дрожжей |
| HP012A | Тест-пластины для экспресс-подсчёта плесневых грибов и дрожжей (метод мембранной фильтрации) | 20 тестов / упаковка | Экспресс-подсчёт плесневых грибов и дрожжей |
| HP004 | Тест-пластины для подсчёта E.coli / колиформ | 20 тестов / упаковка | Подсчёт E.coli / колиформ |
| HP005 | Тест-пластины для детекции Salmonella | 20 тестов / упаковка | Детекция Salmonella |
| HP005E | Среда для обогащения Salmonella | 250 г | Обогащение Salmonella |
| HP006 | Тест-пластины для детекции Cronobacter sakazakii | 20 тестов / упаковка | Детекция Cronobacter sakazakii |
| HP007 | Тест-пластины для детекции Staphylococcus aureus | 20 тестов / упаковка | Детекция Staphylococcus aureus |
| HP008 | Тест-пластины для детекции Listeria monocytogenes | 20 тестов / упаковка | Детекция Listeria monocytogenes |
| HP009 | Тест-пластины для детекции Listeria | 20 тестов / упаковка | Детекция Listeria s |
| HP010 | Тест-пластины для детекции Vibrio parahaemolytius | 20 тестов / упаковка | Детекция Vibrio parahaemolytius |
Тест-пластины для подсчета плесневых микроорганизмов и колиформ
| Код | Название продукта | Спецификация | Предполагаемое применение |
| 60020 | Тест-пластины для общего подсчёта плесневых микроорганизмов | 20 упаковок / коробка (2 пластины / упаковка) | Для тестирования на плесень и дрожжи в воде или других пищевых образцах. |
| 60030 | Тест-пластины для теста на колиформы — I | 10 упаковок / коробка (15 пластин / упаковка) | Для теста на колиформы в воде. |
| 60040 | Тест-пластины для теста на колиформы — II | 10 упаковок / коробка (5 пластин / упаковка) | Для теста на колиформы в воде. |
| 60050 | Тест-пластины для теста на колиформы — III | 10 упаковок / коробка (9 пластин / упаковка) | Для теста на колиформы в воде. |
| 60090 | Антисептические тест-пластины для теста на колиформы | 10 упаковок / коробка (10 пластин / упаковка) | Для теста на колиформы в пищевых продуктах или напитках, содержащих консерванты (бензойная кислота, сорбитол и др.). |
| 60061 | Влажная пластина для теста на колиформы для столовой посуды | 100 упаковок / коробка (2 пластины / упаковка) | Для теста на колиформы на столовой посуде. |
| 60062 | Влажная пластина для теста на колиформы для столовой посуды | 100 упаковок / коробка (2 пластины / упаковка) | Для теста на колиформы на столовой посуде. |
Бренд
HuanKai